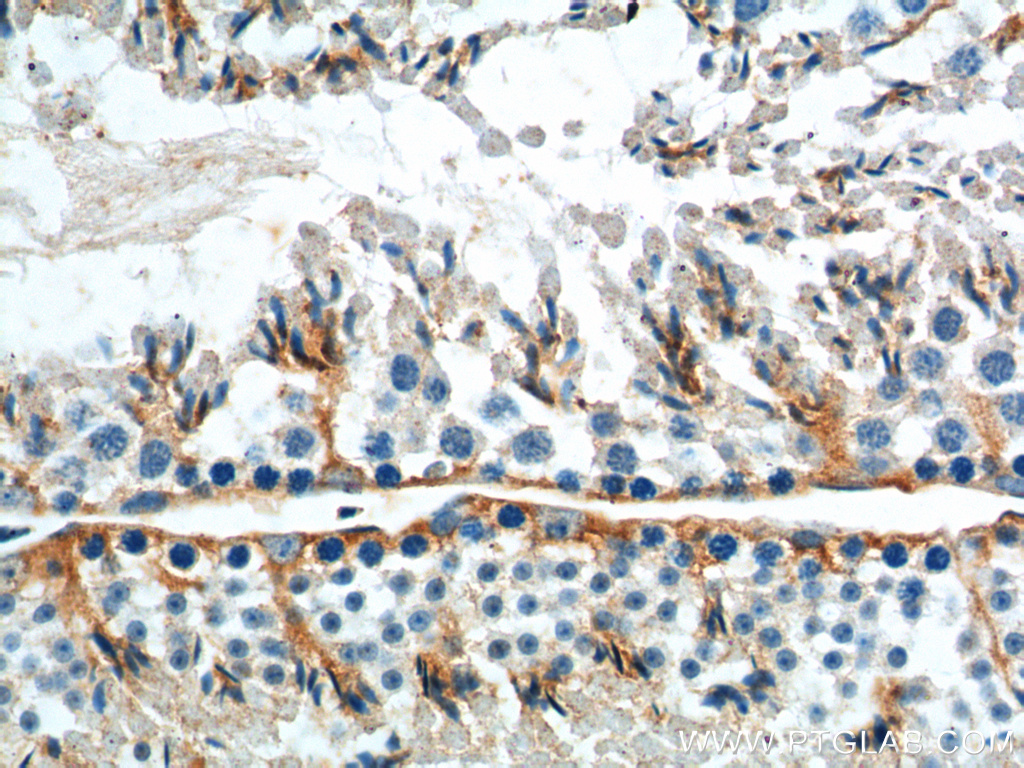

验证数据展示
经过测试的应用
| Positive WB detected in | MCF-7 cells, mouse ovary tissue |
| Positive IHC detected in | mouse ovary tissue, human testis tissue, human ovary tissue, mouse testis tissue Note: suggested antigen retrieval with TE buffer pH 9.0; (*) Alternatively, antigen retrieval may be performed with citrate buffer pH 6.0 |
| Positive FC (Intra) detected in | MCF-7 cells |
推荐稀释比
| 应用 | 推荐稀释比 |
|---|---|
| Western Blot (WB) | WB : 1:1000-1:6000 |
| Immunohistochemistry (IHC) | IHC : 1:500-1:2000 |
| Flow Cytometry (FC) (INTRA) | FC (INTRA) : 0.20 ug per 10^6 cells in a 100 µl suspension |
| It is recommended that this reagent should be titrated in each testing system to obtain optimal results. | |
| Sample-dependent, Check data in validation data gallery. | |
产品信息
19950-1-AP targets GNRHR in WB, IHC, IF, FC (Intra), ELISA applications and shows reactivity with human, mouse samples.
| 经测试应用 | WB, IHC, FC (Intra), ELISA Application Description |
| 文献引用应用 | WB, IHC, IF |
| 经测试反应性 | human, mouse |
| 文献引用反应性 | human, mouse, rat, pig, sheep |
| 免疫原 |
Peptide 种属同源性预测 |
| 宿主/亚型 | Rabbit / IgG |
| 抗体类别 | Polyclonal |
| 产品类型 | Antibody |
| 全称 | GnRH receptor |
| 别名 | GnRH R, GnRH receptor, GnRH-R, GNRHR1, GRHR |
| 计算分子量 | 38 kDa |
| 观测分子量 | 60-70 kDa |
| GenBank蛋白编号 | NM_000406 |
| 基因名称 | GNRHR |
| Gene ID (NCBI) | 2798 |
| RRID | AB_10644155 |
| 偶联类型 | Unconjugated |
| 形式 | Liquid |
| 纯化方式 | Antigen affinity purification |
| UNIPROT ID | P30968 |
| 储存缓冲液 | PBS with 0.02% sodium azide and 50% glycerol, pH 7.3. |
| 储存条件 | Store at -20°C. Stable for one year after shipment. Aliquoting is unnecessary for -20oC storage. |
背景介绍
GNRHR, also named GRHR, belongs to the G-protein coupled receptor 1 family. GNRHR is a receptor for GnRH that mediates the action of GnRH to stimulate the secretion of the gonadotropic hormones luteinizing hormone (LH) and follicle-stimulating hormone (FSH). It mediates its action by association with G-proteins that activate a phosphatidylinositol-calcium second messenger system. Isoform2 of GNRHR may act as an inhibitor of GnRH-R signaling. Defects in GNRHR are a cause of idiopathic hypogonadotropic hypogonadism (IHH). Defects in GNRHR are a cause of fertile eunuch syndrome. The antibody only recognizes the isoform1 of GNRHR. The predicted unmodified molecular weight of the human GNRHR is ~38 kDa, the larger band (50-65 kDa) is likely to represent a glycosylated form of GNRHR.
实验方案
| Product Specific Protocols | |
|---|---|
| FC protocol for GNRHR antibody 19950-1-AP | Download protocol |
| IHC protocol for GNRHR antibody 19950-1-AP | Download protocol |
| WB protocol for GNRHR antibody 19950-1-AP | Download protocol |
| Standard Protocols | |
|---|---|
| Click here to view our Standard Protocols |
发表文章
| Species | Application | Title |
|---|---|---|
Cancer Res Peptide-Drug Conjugate GnRH-Sunitinib Targets Angiogenesis Selectively at the Site of Action to Inhibit Tumor Growth. | ||
Int J Nanomedicine Pseudoephedrine Nanoparticles Alleviate Adriamycin-Induced Reproductive Toxicity Through the GnRhR Signaling Pathway. | ||
Int J Mol Sci Development and Biochemical Characterization of Self-Immolative Linker Containing GnRH-III-Drug Conjugates. | ||
Bioconjug Chem GnRH-Gemcitabine Conjugates for the Treatment of Androgen-Independent Prostate Cancer: Pharmacokinetic Enhancements Combined with Targeted Drug Delivery. | ||
Front Endocrinol (Lausanne) The Anti-proliferative Activity of GnRH Through Downregulation of the Akt/ERK Pathways in Pancreatic Cancer. | ||